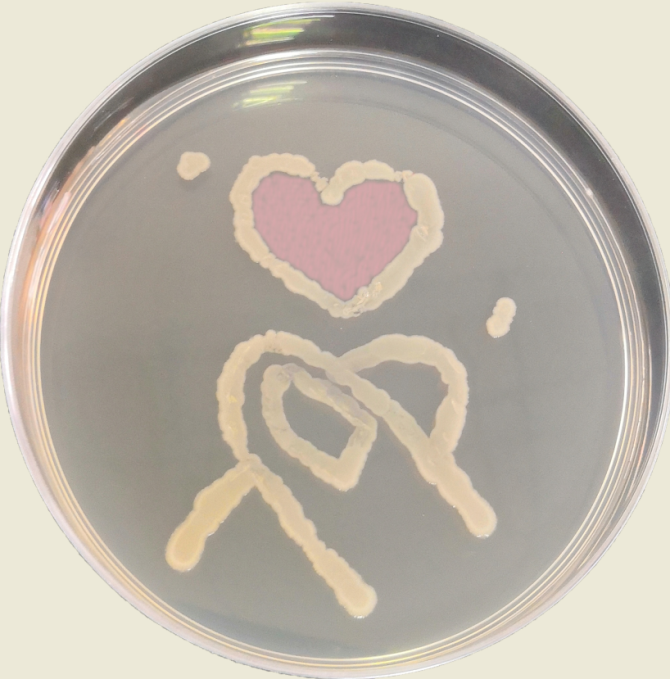
q6.png
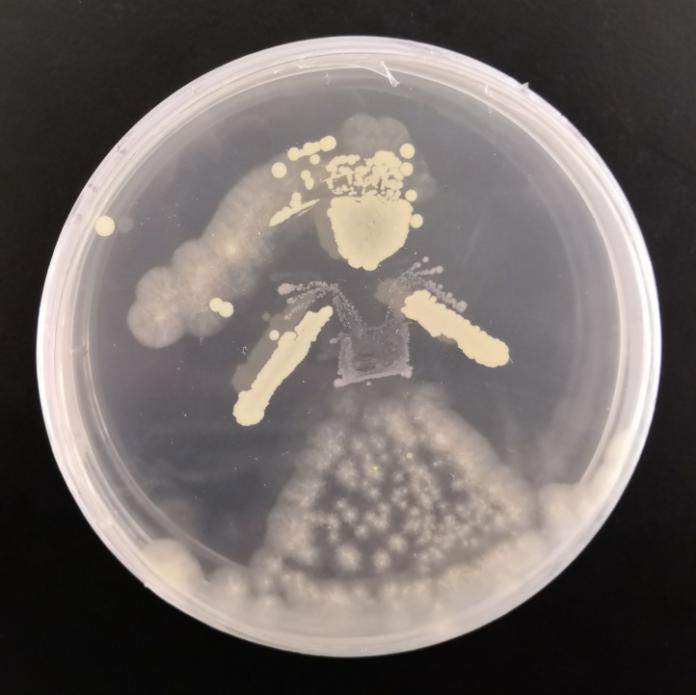
q8.png

微生物好比看不见的精灵,在我们的生活中无处不在,又发挥着至关重要的作用。想起微生物,我们可能会想到微生物酿造的啤酒的特殊香味,也可能会想到面包上的霉菌的黑斑点,想到实验室里培养基和保温箱,但我们可能极少想到这些与衣食住行息息相关的小生物也可以充满艺术的浪漫气息。
刚刚过去的一学期,学院2016级生物工程班举办第一届培养基艺术设计大赛。比赛分为两种形式,一是直接取用微生物在平板培养基上作画,二是利用同学们在微生物实验中已经观察到的图像进行二次创作。作画用的微生物材料包括大肠杆菌和枯草芽孢杆菌等,用于观察并二次创作的图像包括各类霉菌。
请欣赏这些巧合的作品吧——
一、微生物直接作画的作品:白色的枯草芽孢杆菌和插入红色基因的大肠杆菌工程菌在同学们的创作下变成了丰富多彩的形象。

(冠军作品:冠军作品则是用了黑曲霉与枯草芽孢杆菌,形态较干燥紧密的枯草芽孢杆菌菌落构成了面部和躯干,形态较为松散的黑曲霉菌丝就好像拍飘逸又浪漫的裙摆与头纱,可以说是浑然天成。)
其次借助电脑强大的Photoshop等图片编辑软件,同学们的想象力可以继续驰骋,看看他们都有哪些脑洞吧:



(三孢布拉氏霉在同学们的图画中扮演着不同的角色)


(冠军作品:土壤分离的放线菌菌丝细长交错密布,在Photoshop加工后成为了交错的树枝,与花鸟一同构成一幅江南水景图)
培养基微生物作画比赛是一个结合生物工程同学们专业知识、实验技能与创造力和想象力的一项活动,活动形式新颖、内容趣味性十足,同学们展开想象的翅膀各显神通,在学习专业知识之余,不局限于课本,发挥想象学以致用正是我们大学生的活力的体现,相信微生物平板菌作画大赛会越办越好!
文/翁雨晴
图/2016级生物工程班